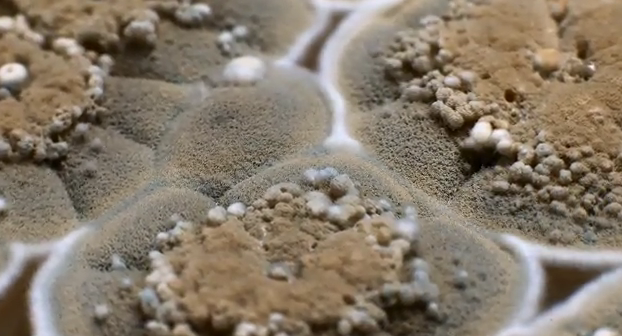

This video is a time-lapse of the mystical-seeming beauty of the salt flat of Uyuni. While this, at times, looks like something out of our world, Uyuni is in Bolivia. The strange reflections are caused by flood water. The flats are the largest in the world, over 10,000KM2, near the Andes and have an altitude […]
Discover Related Tags
Fisheye lens time-lapse of Leonid and Zodiacal light
This impressive time-lapse video was created by Stephane Vetter using a Sigma 8mm fisheye lens. The fisheye lens means you get a truer image of the visible sky. The Leonids is a meteor shower, named after the constellation of Leo as they seem to radiate from that point in the sky. The Lenoids are most […]
The strangely beautiful aspergillus fumigatus botrytis mucor trichoderma cladosporium
Who knew that aspergillus fumigatus botrytis mucor trichoderma cladosporium could be so beautiful? This video uses special techniques to capture the growth of aspergillus fumigatus botrytis mucor trichoderma cladosporium in all its alien beauty. In Pure Spirit Isn’t the video strange? Is it like any other time lapse videos you’ve seen before?
Tom Lowe: Timescapes Rapture
This is a remarkable collection of timelapse and action from photographer of the year 2010; Tom Lowe. Timescales is a portrait of the modern Southwest in America. This video showcases the wonders of the Southwest landscapes and skyscapes peppered with some fantastic clips and images. In Pure Spirit What do you think? Do you have […]
Breathtaking arctic light time-lapse
Amazing time-lapse videos seem to be all the rage on the internet. I recommend you check out this footage from the European Southern Observatory, El Teide and the Canary Sky to catch up on the vids that have already impressed the web. This video was filmed in the Arctic; in the archipelago Lofoten in Norway […]
Stunning time-lapse video from the European Southern Observatory
The images in this time lapse video are breath taking – they show nature with clarity and perfection. If your computer can manage it, this video is best watched by selecting the higher P rating in YouTube (down in the bottom menu bar, just along from the timestamp) and flipping to full screen. At times […]
Beautiful “Canary Sky” time lapse video
This collection of fantastic time-lapse photographs was taken in Tenerife at some 2,000 meters above sea level. It took more than a year to film all the footage. Rather unusually for time-lapse, the camera was also set on horizontal rails, sometimes a dolly vertical and spindles with horizontal and vertical movements. These allow the camera […]
Beautiful time-lapse video from El Teide
El Teide is Spain’s highest mountain and home to the Teide Observatories – which many people consider to be one of the very best observatories on Earth. Norwegian photographer Terje Sorgjerd suffered an exhausting trip, hardly any sleep and a heavyweight of equipment in order to put this time-lapse video together. In Pure Spirit What […]